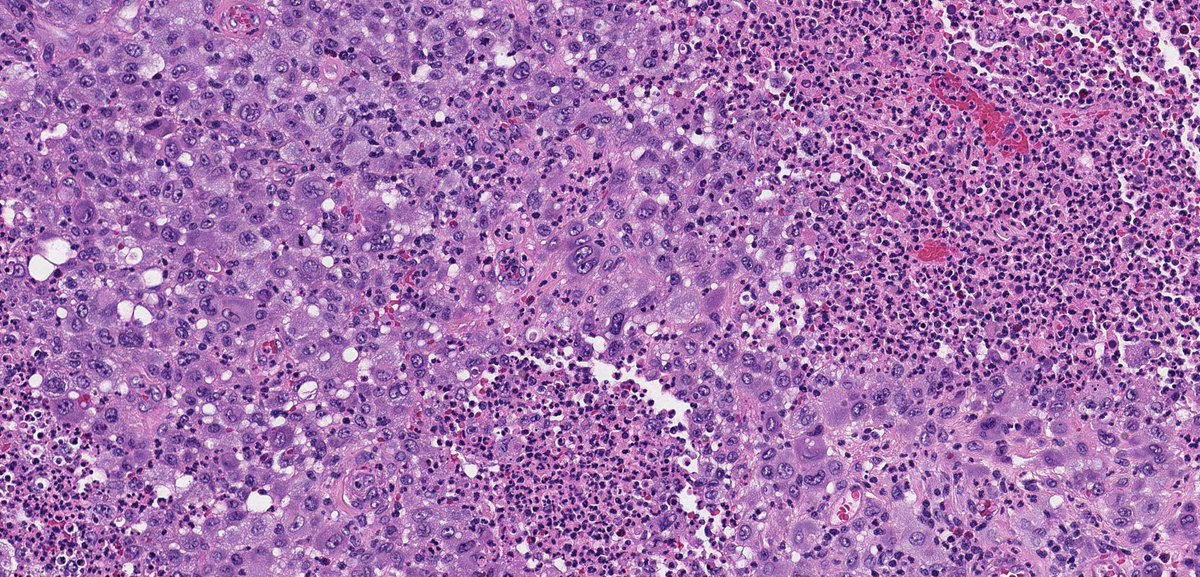
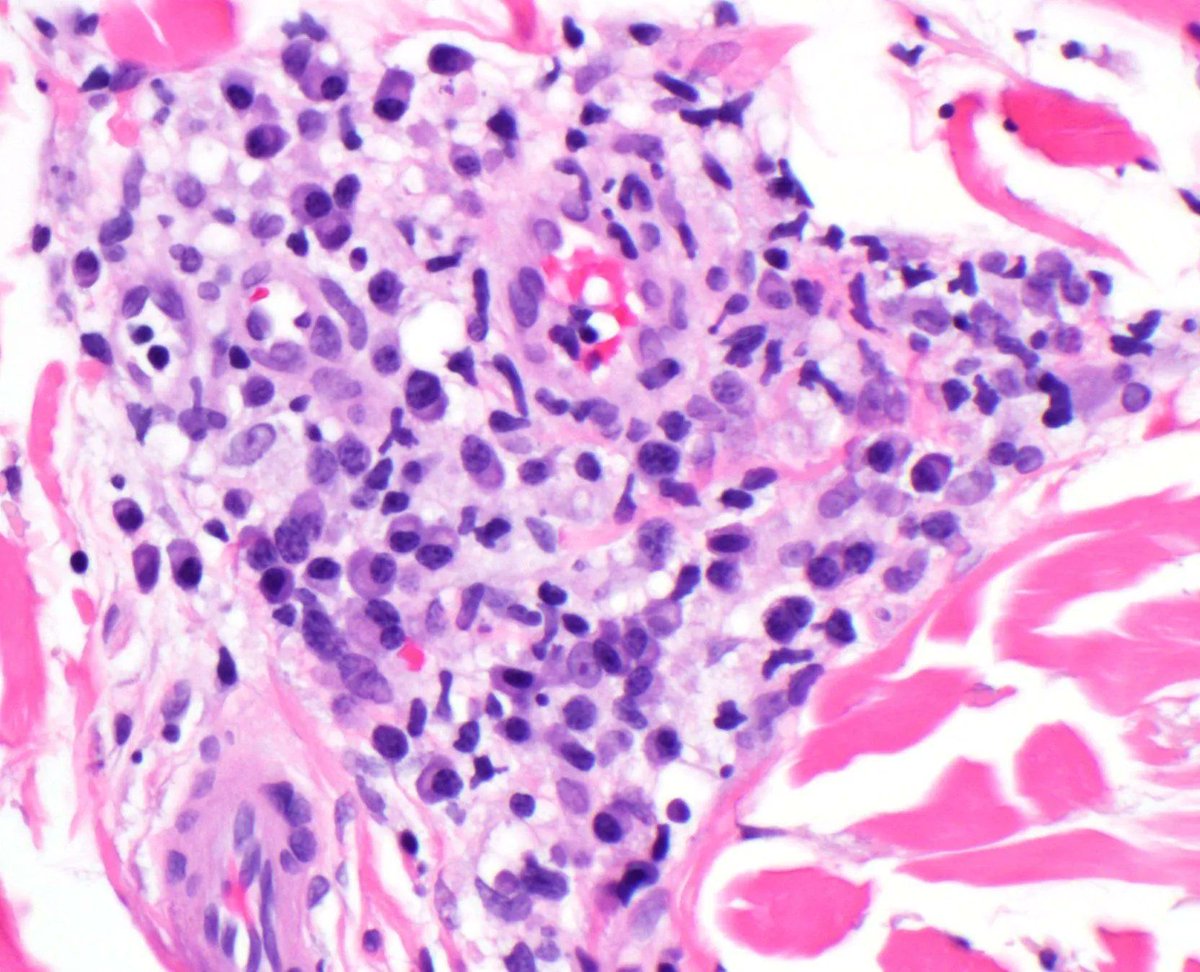
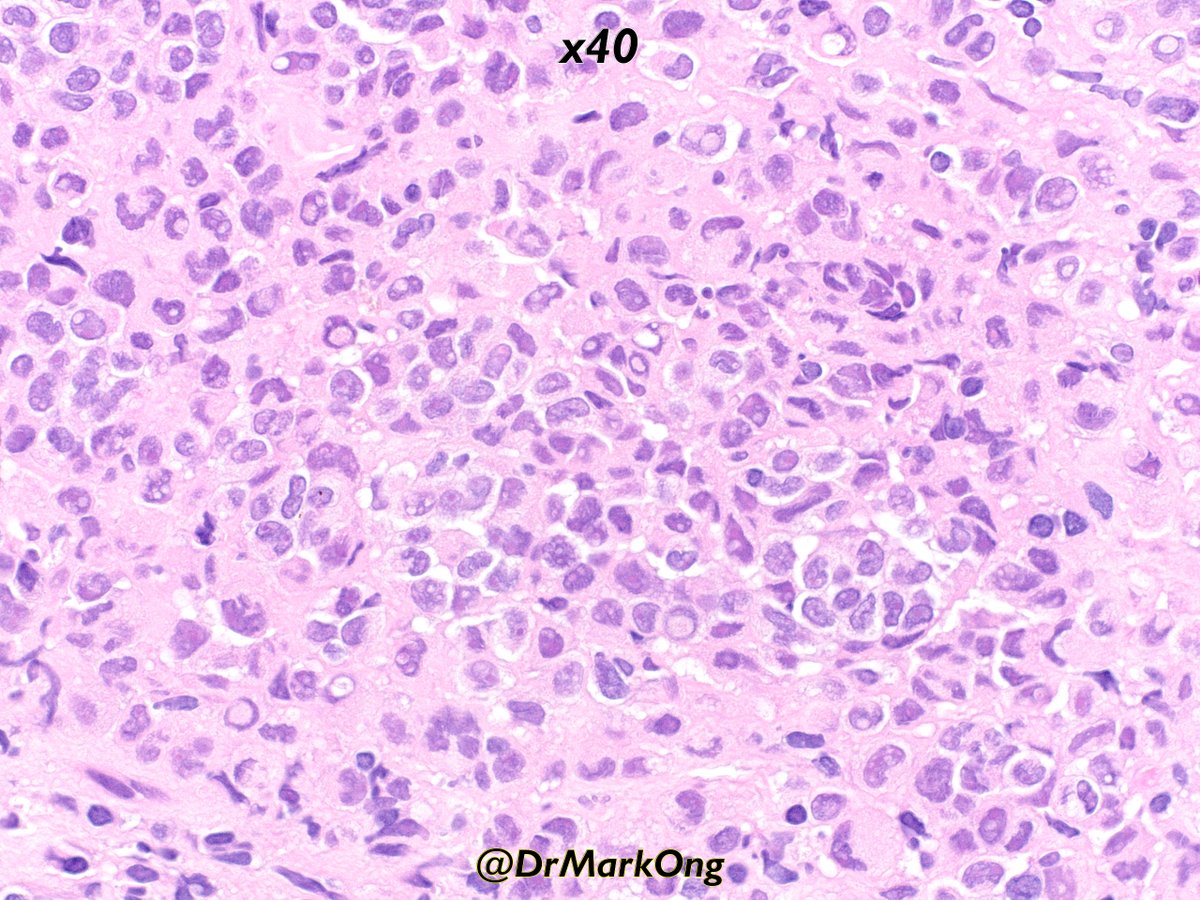
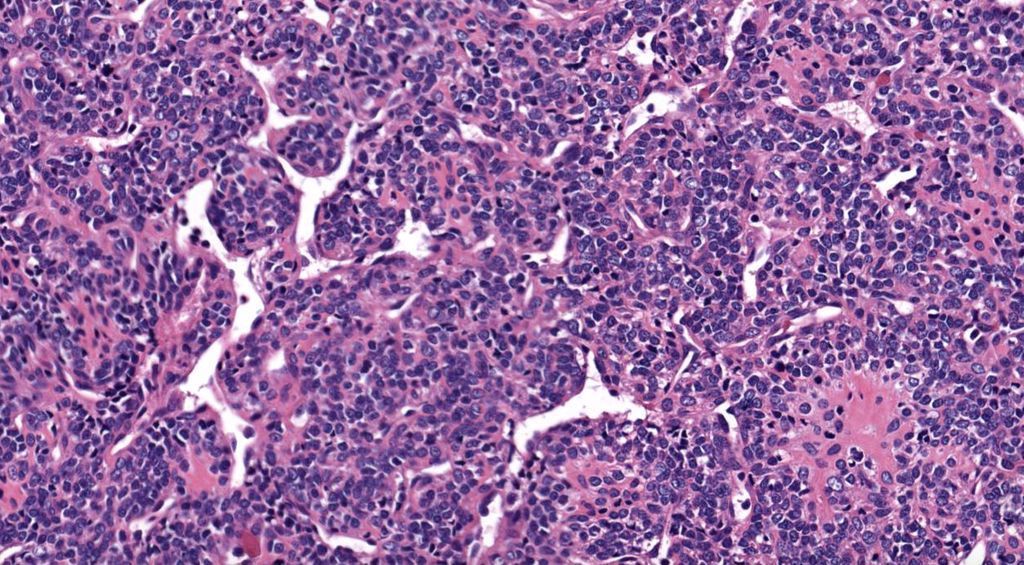

Ygl
@fttud4d3cm5uunx
ID: 982092988112228352
06-04-2018 03:09:49
10,10K Tweet
590 Takipçi
2,2K Takip Edilen


LANGERHANS CELL SARCOMA: Rare tumor of dendritic family often in dermis/subcutis. Sheets of bizarre pleomorphic/epithelioid cells. Rare dx not to forget about! (+) Langerin, S100, CD1a. #bstpath Jerad Gardner, MD @histiocytosisX Steven Billings, MD Scott Lauer, MD Rajiv M. Patel, M.D.

75-year-old male with a 4 cm mass in the lower pole of the right kidney. CA9 diffusely positive = CCRCC with a cute morphological appearance. #gupath GU Pathology Society (GUPS) International Society of Urological Pathology